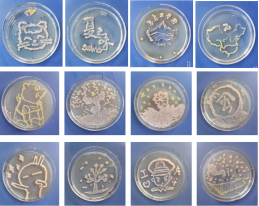

食品科学与工程专业介绍
一、专业名片
专业名称:食品科学与工程 专业代码:082701
修业年限:4年 学位授予:工学
二、专业介绍
1.专业介绍
食品科学与工程专业于2009年开始招生,2014年被评为山东省第一批“民办本科高校优势特色专业”,2019年被评为省级一流本科专业,2023年该专业教研室被评为山东省普通本科高等学校示范性基层教学组织。专业建设之初依托中国海洋大学食品科学与工程学院,传承了其特色的人才培养模式和优良教学作风。
根据人才培养立足青岛、面向周边的要求,结合人才市场对食品科学与工程专业学生的职业能力需要,发展“产、学、研、销”一体化的人才培养模式,旨在培育知识结构优、实践能力佳、创新创业意识强的“应用型”人才。
该专业以化学、生物学和工程学为基础,涵盖食品科学、食品加工工艺及过程、食品检验等内容,着重研究食品的物理、化学及生物性质、食品加工原理及加工工艺、食品贮藏理论、分析检验、食品资源的综合开发和利用等。
2.专业优势
(1)产学研协同育人
专业与百胜餐饮集团、青岛新希望琴牌乳业有限公司、青岛明月海藻集团有限公司、华测检测技术股份有限公司等多家企业进行校企合作,建立了“引企入校、校企融合”的人才培养模式,使教学内容与职业标准相对接、教学过程与生产过程相对接,培养符合行业需要的应用型人才。近年来,专业内多名学生在实习基地完成毕业实习并参加工作。
|
实习实训中的学生风采
(2)实验设备先进,实验室面向学生开放
本专业拥有省级优势特色实验室,实验设施齐备,在满足日常教学、培养学生专业实践能力的同时,还面向专业内全部学生开放,可满足学生进行创新创业、科学研究等创新素质培养的需要。


虚拟仿真实验室 有机化学实验室


生物化学实验室 精酿酒发酵实验室


高效液相色谱仪 高效气相色谱仪
(3)教学质量稳步提升
不断强化毕业生考研升学导向,毕业生中考研人数和升学率明显提高。专业内学生在优秀教师的带领下,获批多项国家级省级创新创业项目。
(4)优秀的师资队伍
本专业拥有一支学历水平高、治学严谨、素质过硬的师资队伍。除了为学生传授专业的理论及实践知识、培养学生的创新精神和实践能力外,专业教师还注重对学生的人文关怀,关注学生的全面发展。
(5)以赛促教,以赛促学
积极组织学生参加校外创新创业及专业比赛。此外,本专业每年度还在校内开展“美食杰”、“食品创意大赛”、“实验技能操作大赛”等比赛,鼓励学生积极参与,帮助学生在比赛中提升专业实践技能和创新能力。

食品创意大赛

“百分店长”创新大赛

食品创意大赛学生作品 微生物培养皿艺术大赛
三、学院介绍
1.培养目标
食品科学与工程专业面向食品及饮料生产企业,培养能够较好适应地方经济社会发展需要,具有良好的思想品质、职业道德与文化素养,具备食品原料综合利用、食品加工、生产质量控制、食品保藏、食品理化及微生物检验分析等方面的基本理论与技能,可以在食品生产、卫生监督、安全管理、食品检验检疫等企事业单位从事食品加工、生产管理、品质控制、检验检疫等方面工作的具有创新意识的高素质工程技术应用型人才及社会主义合格建设者和接班人。
2.课程设置
(1)基础课程
无机及分析化学、有机化学、生物化学、食品微生物学、食品化学、食品原料学、食品安全学、无机及分析化学实验、有机化学实验、生物化学实验、食品微生物学实验等。
(2)特色课程
食品工艺学、食品工程原理、食品保藏技术、食品检验与分析、食品机械与装备、食品工厂设计、食品安全与质量控制、食品添加剂、食品营养学、食品包装学、食品工艺学实验、食品检验与分析实验等。
3.就业去向
(1)可在各类大型食品企业从事生产工艺设计、产品开发、质量检测、经营管理等工作。
(2)可考取各类政府或事业编制部门,如食品药品质量监督局、卫生防疫、进出口检验检疫、市场监督管理部门、高等院校、科研机构。
(3)可考取食品或相近专业研究生,也可申请国外高校研究生继续出国深造。
四、学生成果及优秀毕业生
1.学生成果


国家奖学金 山东省高等学校优秀学生干部


山东省高等学校优秀学生 青岛市千名优秀大学生


大学生创业综合模拟大赛省二等奖 食品加工与安全创新设计大赛省一等奖


山东省青年科普优秀作品 百分店长大赛华北赛区复赛季军


全国大学生食品安全知识竞赛一等奖 全国大学生英语单词大赛一等奖
2.优秀毕业生
|
|
|
||||||||||||
|
|
|
||||||||||||
|
|
|
||||||||||||
|
|
李展,2024届食品科学与工程专业毕业生,考取天津科技大学食品加工与安全专业研究生。 |